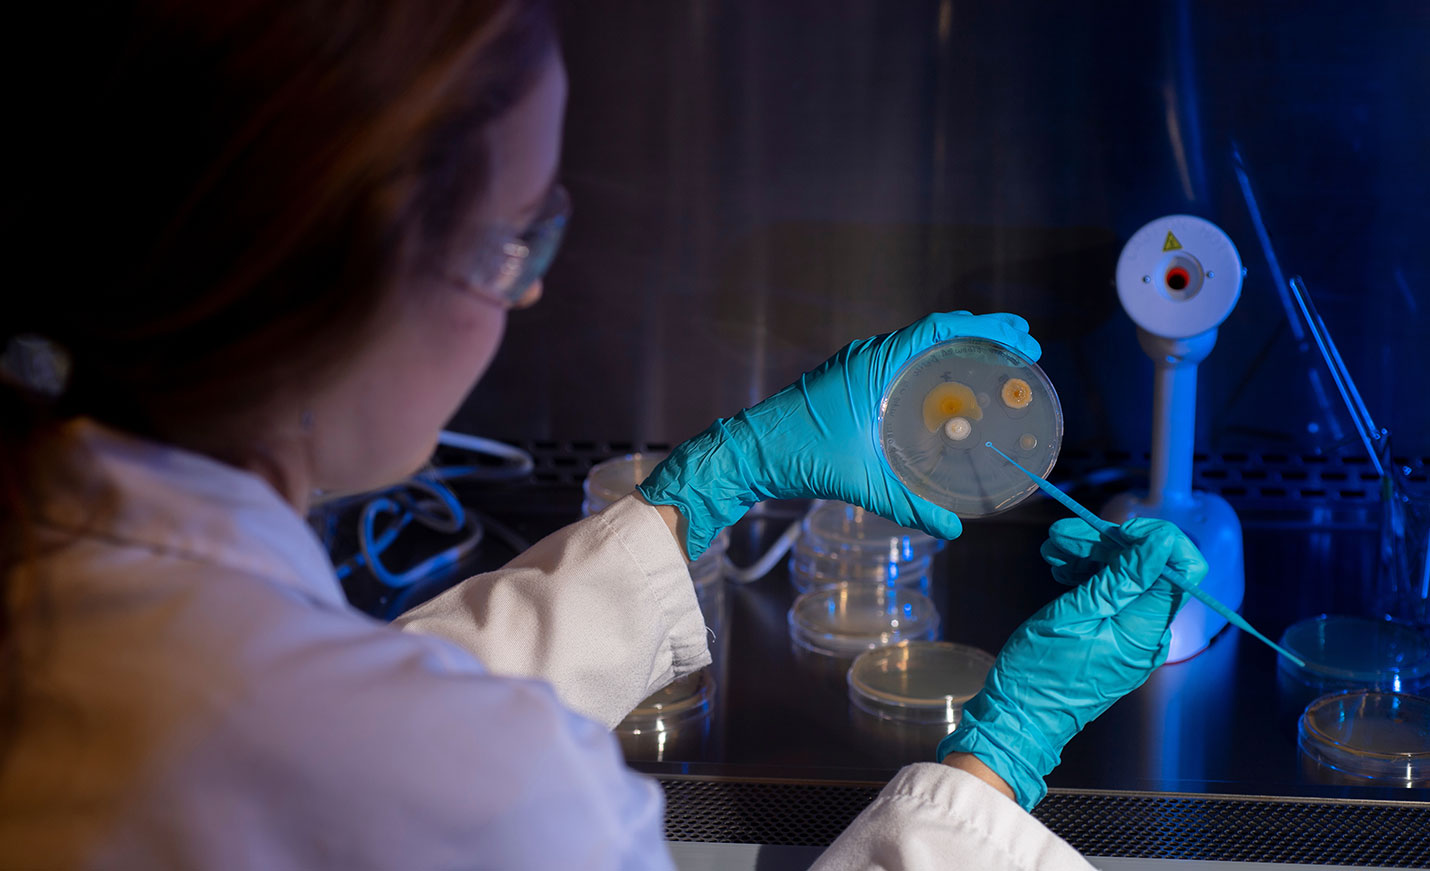

Related Programs
Biology, B.A.
Designed to create professionals who are qualified for a wide array of positions working in the biological sciences.
Biology, B.S.
Designed to meet the needs of BIO majors who may wish to pursue further education in graduate school in Biology or professional schools in the health sciences.
Chemistry, B.S.
A rigorous program emphasizing hands-on learning, the B.S. in Chemistry prepares you to pursue a a graduate degree or to directly start a career in chemistry.
Biochemistry, B.S.
The B.S. in Biochemistry provides students with a firm foundation in the quantitative areas essential to all of chemistry, such as general, organic and biophysical chemistry. In addition to the foundational courses, the curriculum provides a thorough background in cell biology, genetics and molecular biology, to establish the context for biochemical processes.